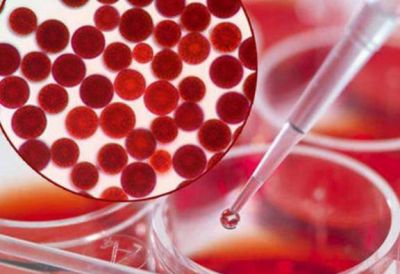
1236187011311 蝦青素涂臉后色素沉著怎么辦

蝦青素可能大家都不知道這是什么東西?其實簡單來說蝦青素是自然界中最強的抗氧化劑,具有“超級維生素E”的美譽,其抗氧化活性是維生素E的550倍,能夠有效地保護皮膚免受紫外線(UVA,UVB)的損害,在皮膚受到光照時消耗腐胺,作為潛在的光保護劑,用于阻止皮膚光老化防治誘發皮膚癌。下面我們就科普下蝦青素吧!
蝦青素是什么?
蝦青素是一種酮或類胡蘿卜素,色澤為粉紅色,具脂溶性,不溶于水,可溶于有機溶劑。 亦稱蝦黃素。從河螯蝦外殼,牡蠣和鮭魚等水生動物體內發現的一種紅色類胡蘿卜素,化學名3,3′-二羥基-4,4′-二酮基-β,β′-胡蘿卜素。在體內可與蛋白質結合而呈青色、藍色。特別是水生動物如蝦、蟹、魚和鳥類的羽毛中,起顯色的作用。 蝦青素是一種斷鏈抗氧化劑。具有極強的抗氧化能力,可以清除二氧化氮、硫化物、二硫化物等,也可降低脂質過氧化作用,有效的抑制自由基引起的脂質過氧化蝦青素。同時,有抑制腫瘤發生,增強免疫力,清除體內自由基等多方面的生理作用,對紫外線引起的皮膚癌有很好的治療效果,對糖尿病引起的眼病也有防治作用,在保健品、醫藥、化妝品、食品添加劑以及水產養殖等方面具有廣闊的應用前景。

蝦青素對皮膚有什么好處?
1、美白淡斑、防曬
夏季的時候,很多人不想被強烈的陽光灼傷,因為紫外線會使皮膚變黑,傷害皮膚。而蝦青素可以美白淡斑和防曬。
2、減少皺紋
吃蝦青素還可以減少皺紋,正好還新出了蝦青素面膜,外敷一下。
3、對抗皮膚老化
人體皮膚的老化是由于身體內的自由基積累過多所導致的,蝦青素具有抗氧化、抗衰老、清除自由基的作用。
蝦青素可以直接添加在護膚品里嗎?
蝦青素可以直接添加在護膚品里,蝦青素應用的一個重要領域就是美容化妝。

蝦青素涂臉后色素沉著怎么辦?
臉就變黃的原因有很多,例如,由于最近一直在很多的吃黃色的食物,例如桔子,紅蘿卜,冬瓜等,這種黃色素便會體現在臉部,出現面色變黃的狀況;也可能是由于最近一直經常熬夜,休息不好,影響了肝臟的祛毒,造成了臉黃;也有可能是由于人體出現了一些病癥,例如比較嚴重的貧血,便會有臉色暗沉,嘴唇發白的狀況;也有可能是出現了肝臟的病癥等,需要到醫院門診查一下肝功能來診斷。
其實蝦青素許許多多的美容產品中都會有的一種成分,其是人為合成的一種物品,含有非常多的對人體有好處的維生素。對護膚的美容效果真的很不錯的!

評論